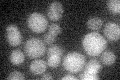
YOR155C
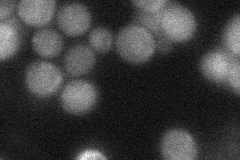
YOR155C
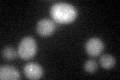
YOR155C

View description
Inosine 5'-monophosphate (IMP)-specific 5'-nucleotidase, catalyzes the breakdown of IMP to inosine, does not show similarity to known 5'-nucleotidases from other organisms
Localization:
Intensity:
Fold change:
Significance:
-
C’ GFP library in SD
below threshold17.17 -
N' NOP1pr-GFP in SD

punctate143.668 -
N' TEF2pr-mCherry in SD

punctate262.516 -
N' NATIVEpr-GFP in SD
cytosol,punctate36.5966 -
N' TEF2pr-VC and Cyto-VN in SD

#N/A0 -
C’ GFP library in SD+DTT
cytosol20.371.18No -
C’ GFP library in SD+H2O2

cytosol20.911.21No -
C’ GFP library in Starvation Media

cytosol24.941.45No -
C’ GFP library on the background of Pup2-DaMP

below threshold -
C’ GFP library on the background of CCT mutant

below threshold17.43141.01496No
